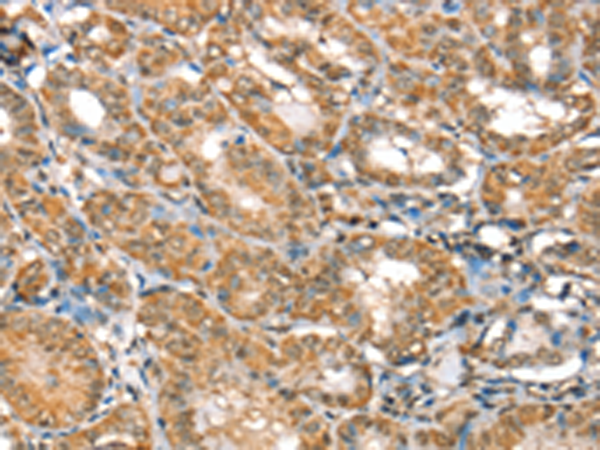
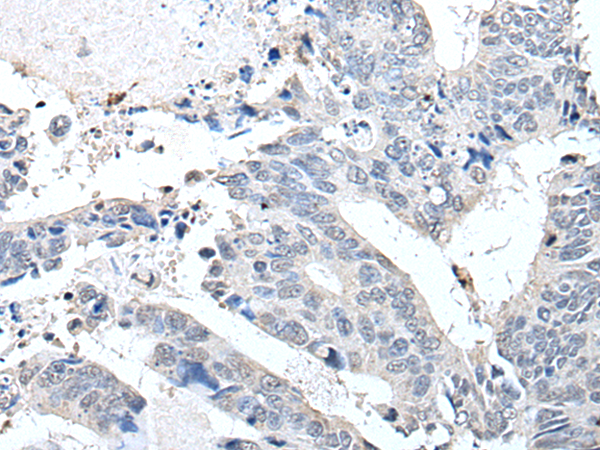

-
分类: 科研抗体货号: P08632别名: P2; MP2; FABP8; M-FABP应用: WB,IHC反应种属: Human, Mouse
-
分类: 科研抗体货号: P08654别名: IA2; IA-2; ICA512; R-PTP-N; IA-2/PTP应用: IHC反应种属: Human, Mouse, Rat
-
分类: 科研抗体货号: P08650别名: NRP; FIP2; HIP7; HYPL; ALS12; GLC1E; TFIIIA-INTP应用: IHC反应种属: Human, Mouse, Rat
-
分类: 科研抗体货号: P08666别名: H12.3; HLC-7; PIG21; GNB2L1; Gnb2-rs1应用: WB,IHC反应种属: Human, Mouse, Rat
-
分类: 科研抗体货号: P08683别名: MDT1; CGI82; PSDR1; RALR1; SCALD; ARSDR1; HCBP12; SDR7C1应用: IHC反应种属: Human, Mouse
-
分类: 科研抗体货号: P08665别名: RAB9应用: WB,IHC反应种属: Human, Mouse, Rat
-
分类: 科研抗体货号: P08682别名: G15; H37; RMB5; LUCA15应用: WB,IHC反应种属: Human, Mouse, Rat
-
分类: 科研抗体货号: P08664别名: RAB4; HRES1; HRES-1; HRES-1/RAB4应用: IHC反应种属: Human, Mouse, Rat
-
分类: 科研抗体货号: P08681别名: RBQ3; SWD1应用: WB反应种属: Human, Mouse
-
分类: 科研抗体货号: P08663别名: GS2; RAM; RAB27; HsT18676应用: WB,IHC反应种属: Human, Mouse, Rat

鄂公网安备42018502007531号
鄂公网安备42018502007531号

